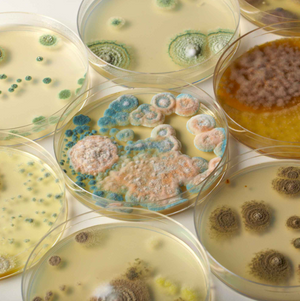

9341570142051
Revolting Science is a gross science kit that allows kids to explore the fascinating world of bacteria with hands-on experiments. Featuring easy-to-follow instructions and high-quality materials, it is an ideal tool to introduce kids to microbial science in a fun and interactive way.
Ages 8 years +